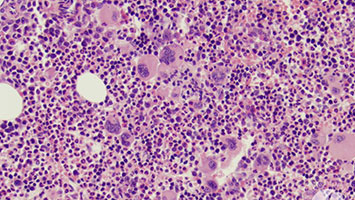
myeloproliferative-neoplasms

Types of Blood Cancer

Myelodysplastic Syndromes (MDS)
Disorders where bone marrow fails to produce healthy blood cells.
Read More
Myeloproliferative Neoplasms (MPN)
Assistance with obtaining high-quality medications at discounted rates for eligible patients.
Read More


